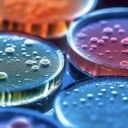

Máš nedostatek banánů ? Jak na ně?
- banány získáš za aktivitu na webu: vytvoř materiály, testy nebo hodnocení vyučujících. Za získané banány pak stáhneš další materiály nebo je vyměníš za dárky. Více informací najdeš v příručce.
- banány si také můžeš jednoduše zakoupit a podpořit tak aktivní uživatele a rozvoj webu: